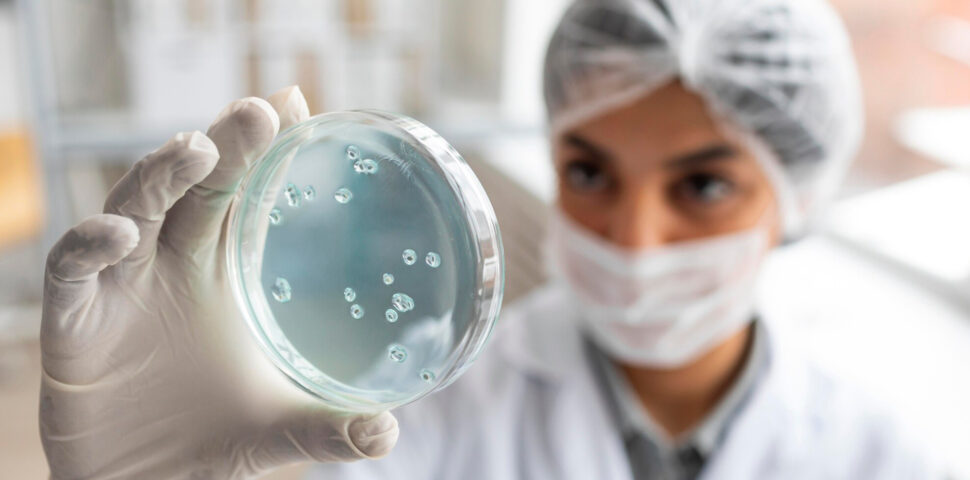
Impactos clínicos da resistência bacteriana

O norovírus é um dos principais agentes causadores de gastroenterite aguda no mundo, sendo altamente contagioso e de rápida transmissão. Diferentemente de outras infecções gastrointestinais, o norovírus possui uma alta taxa de mutação e variabilidade genética, o que dificulta a criação de imunidade duradoura. Além disso, sua transmissão eficiente em ambientes coletivos faz com que surtos sejam frequentes, especialmente em locais como creches, escolas, hospitais e cruzeiros.
Neste artigo, explicaremos como ocorre a transmissão, quais são os sintomas, como tratar a doença e as melhores estratégias de prevenção. Continue a leitura para saber mais!
O que é o norovírus?
O norovírus é um vírus de RNA de cadeia simples, pertencente à família Caliciviridae. Ele é altamente resistente a condições adversas do ambiente, como temperaturas extremas e desinfetantes comuns, contribuindo para a disseminação em larga escala.
Esse vírus pode permanecer viável por longos períodos em superfícies contaminadas, na água e em alimentos, tornando-o um dos patógenos mais persistentes. A carga viral necessária para causar infecção é baixa, o que significa que uma pequena quantidade do vírus pode desencadear sintomas severos em indivíduos suscetíveis.
Sabe-se que o norovírus é responsável por aproximadamente 20% dos casos globais de gastroenterite aguda. Tal capacidade de resistência e disseminação amplia sua relevância como um agente de surtos de gastroenterite, principalmente em populações vulneráveis.
Quais são as formas de transmissão?
A transmissão do norovírus se dá predominantemente por via fecal-oral, ou seja, pela ingestão de partículas virais presentes em fezes ou vômitos de indivíduos infectados. O contágio pode acontecer de diferentes maneiras, sendo o contato direto (particularmente em espaços compartilhados) uma das principais formas de disseminação, uma vez que pequenas partículas virais podem ser transferidas facilmente de uma pessoa para outra.
Outra via importante de transmissão é o consumo de alimentos e água contaminados. Alimentos crus ou mal higienizados, como vegetais folhosos e frutos do mar, são fontes frequentes de surtos, existindo a possibilidade de serem contaminados tanto na origem quanto durante o manuseio e preparo. A contaminação de superfícies e objetos também é um fator crítico para a disseminação do vírus.
O norovírus pode sobreviver por semanas em utensílios, bancadas, maçanetas e banheiros, e sua eliminação eficaz exige produtos específicos de desinfecção. Essa característica faz com que a transmissão ocorra rapidamente, sobretudo em locais de grande circulação.
Quais são os sintomas mais comuns?
Os sintomas costumam surgir entre 12 e 48 horas após a exposição ao vírus e, em geral, persistem por um período de um a três dias. O quadro clínico é usualmente caracterizado por diarreia aquosa e intensa, acompanhada por vômitos frequentes, que podem levar a uma desidratação severa.
O paciente pode ainda apresentar náuseas intensas, dores abdominais e mal-estar generalizado. Febre leve, dores musculares e fadiga também são comuns, com maior ocorrência nos primeiros dias da infecção.
Em crianças pequenas, idosos e indivíduos imunossuprimidos, os sintomas podem ser mais graves, prolongando-se por mais tempo e levando a complicações como desidratação severa, desequilíbrio eletrolítico e necessidade de hospitalização. A severidade da infecção depende de diversos fatores, incluindo a carga viral e o estado imunológico do paciente.
Existe tratamento para a infecção por norovírus?
Atualmente, não há um tratamento específico para eliminar o norovírus do organismo, e a abordagem clínica se concentra no alívio dos sintomas e na prevenção de complicações.
Uma estratégia de manejo é a reidratação, que pode ser realizada por via oral em casos leves a moderados, com o uso de soluções eletrolíticas para a reposição de líquidos e sais minerais perdidos durante os episódios de diarreia e vômitos.
Em casos graves, especialmente populações de risco, pode ser necessária a administração de fluidos por via intravenosa para evitar a desidratação. Adicionalmente à hidratação, o uso de medicamentos sintomáticos pode ser considerado, a fim de controlar a febre e o desconforto gástrico, sempre sob orientação médica. O repouso e uma alimentação leve e equilibrada também são fundamentais para a recuperação.
Vale ressaltar que antibióticos não são eficazes contra o norovírus, pois se trata de uma infecção viral e não bacteriana.
Como é feita a prevenção?
A prevenção do norovírus requer uma abordagem abrangente, que inclui higiene pessoal rigorosa, cuidados na manipulação de alimentos e desinfecção ambiental. Para reduzir o risco de infecção, algumas medidas de prevenção são cruciais:
- higiene pessoal, como a lavagem das mãos com água e sabão por pelo menos 20 segundos, sendo essencial antes das refeições, após o uso do banheiro e após o contato com superfícies de alto toque; o uso de álcool em gel também pode ser útil;
- segurança alimentar por meio da higienização correta de frutas e vegetais, do cozimento adequado de carnes e frutos do mar, e do armazenamento correto de alimentos;
- limpeza e desinfecção de superfícies constantemente tocadas, como maçanetas, torneiras e bancadas; devem ser feitas com produtos desinfetantes eficazes contra vírus;
- isolamento de pessoas contaminadas até 48 horas após a melhora dos sintomas.
Como vimos, o norovírus é responsável por grande parte dos casos de gastroenterite aguda. Com a conscientização e boas práticas de higiene e prevenção, os surtos da doença podem ser evitados. E não custa reforçar: caso apresente sintomas persistentes, busque orientação médica. Para saber mais sobre gastroenterites, leia nosso conteúdo sobre o que são gastroenterites?
Sabin avisa:
Este conteúdo é meramente informativo e não pretende substituir consultas médicas, avaliações por profissionais de saúde ou fornecer qualquer tipo de diagnóstico ou recomendação de exames.
Importante ressaltar que diagnósticos e tratamentos devem ser sempre indicados por uma avaliação médica individual. Em caso de dúvidas, converse com seu médico. Somente o profissional pode esclarecer todas as suas perguntas.
Lembre-se: qualquer decisão relacionada à sua saúde sem orientação profissional pode ser prejudicial.
Referências:
Cavicchio L, Laconi A, Piccirillo A, Beato MS. Swine Norovirus: Past, Present, and Future. Viruses. 2022;14(3):537. Published 2022 Mar 5. doi:10.3390/v14030537
Ford-Siltz LA, Tohma K, Parra GI. Understanding the relationship between norovirus diversity and immunity. Gut Microbes. 2021;13(1):1-13. doi:10.1080/19490976.2021.1900994
Estes MK, Prasad BV, Atmar RL. Noroviruses everywhere: has something changed?. Curr Opin Infect Dis. 2006;19(5):467-474. doi:10.1097/01.qco.0000244053.69253.3d